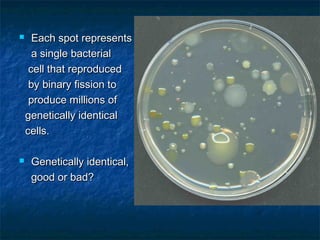
 Each spot representsEach spot represents
a single bacteriala single bacterial
cell that reproducedcell that reproduced
by binary fission toby binary fission to
produce millions ofproduce millions of
genetically identicalgenetically identical
cells.cells.
 Genetically identical,Genetically identical,
good or bad?good or bad?

Prokaryotes like bacteria and archea make up the human microbiome, comprising 1-3% of the human body mass. Bacteria are some of Earth's oldest life forms and come in various shapes. They have diverse metabolic functions and can live in extreme environments. Some bacteria engage in symbiotic relationships with humans and support functions like digestion. While many bacteria are beneficial, certain pathogens can cause diseases. Advances like antibiotics revolutionized medicine but their overuse led to increased antibiotic resistance in bacteria.